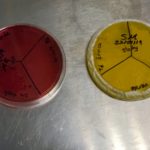

- Las nanopartículas se utilizarán para elaborar un ungüento para heridas con función desinflamatoria-antibiótica y un filtro de agua con acción bactericida de mayor duración.
- Este nuevo método reduce a treinta minutos el tiempo de eliminación de bacterias.
El Dr. Sergio Gama, académico e investigador de la Universidad del Valle de México Campus Toluca, desarrolló un método sustentable y biodegradable para matar bacterias, a partir de nanopartículas de plata en soporte de hueso de bovino y sintetizadas con té de árnica y té verde.Las nanopartículas podrían ser utilizadas parala purificación de agua y tratamiento de heridas.
El objetivo de la investigación titulada Silver nanoparticles supported on bovine powder used as bactericide, fue realizar una síntesis química sustentable de bajo costo que tuviera la capacidad de eliminar bacterias, tales como, E Coli y Staphylococcus aureus, así como reducir el tiempo del efecto bactericida.
El Dr. Gama, quién también es especialista en Ciencias de la materia, explicó que la plata ha sido utilizada desde hace tiempo como bactericida -principalmente para desinfectar agua-. Mencionó también que existen diferentes métodos que sintetizan la plata.
La bacteria E coli afecta los glóbulos rojos y los riñones y la Staphylococcus aureus tiende a infectar la piel. Las bacterias pueden viajar por el torrente sanguíneo e infectar prácticamente cualquier parte del organismo, indicó.
En esta investigación se unieron dos campos, la Ciencia de los materiales y la Biología, la principal aportanción consiste en dar un soporte con hueso de bovino a la nanopartícula para re-utilizarlas en otras reacciones y otros procesos. Las nanopartículas se pueden recuperar fácilmente mediante un filtrado o dejando precipitar el sólido y retirando el líquido, ya que generalmente estas son desechadas después de su uso.
Los sistemas que ya existen son de medios acuosos, por lo que es imposible recuperar las nanopartículas, por otro lado, existe un riesgo con el sistema acuoso ya que pueden viajar al torrente sanguíneo y causar algunas enfermedades.
El investigador explicó que durante su investigación logró un sistema barato, biodegradable, de desecho como es el hueso -en el que quedan ancladas las partículas-, sin embargo, al observar los resultados, identificó que podría dar una aplicación médica y podía evitar químicos para conseguir las nanopartículas, así fue que probó la alternativa de utilizar té para la síntesis.
Recordó que el té es un antioxidante que, al proporcionar iones, ayuda a reducir la partícula de plata y conseguir las nanopartículas. “El té verde y el té de árnica, le dan iones a la plata para que se pueda volver plata metálica, que fue lo que se buscó para realizar este sólido”.
Con este método es posible controlar el tamaño y la cantidad de partículas; estas partículas metálicas tienen iones positivos, mientras que la pared celular de las bacterias tiene cargas negativas, por lo tanto, se sienten atraídas hacia la plata metálica, al atraer la plata métalica la pared celular de la bacteria, queda sin la posibilidad de respirar y de reproducirse, por lo tanto, muere.
Respecto a las bacterias, E Coli puede provocar problemas gastrointestinales graves, se encuentra en agua no tratada. Es por ello que se propone utilizar estas nanopartículas para purificación de agua (integrándolas al filtro) ya que los filtros convencionales son cambiados constantemente porque los cartuchos se llenan de bacterias, en cambio las nanopartículas las matan.
De acuerdo a las pruebas realizadas en laboratorio para purificar 10 litros de agua contaminada con bacterias, se necesitan sólo 7.5mg de plata en tamaño nanométrico.
Por otro lado, el Staphylococcus aureus -bacteria con varias parecedes celulares y por lo tanto más difícil de combatir- surge por la mucosa pero se puede trasladar a heridas y llagas. De ahí la propuesta de utilizar las nanopartículas para elaborar un ungüento de árnica, que además de que tendría la función desinflamatoria funciona como antibiótico.
---------------------------------------------------------------
La Universidad del Valle de México, desde hace más de 65 años se dedica a ofrecer educación superior de calidad, actualmente tiene 23 campus y un Campus Online distribuidos en la República Mexicana. Cuenta con la A7, la máxima acreditación de calidad institucional, otorgada por FIMPES 2025-2032. Con 255 programas inscritos en el Padrón de Alto Rendimiento Académico del EGEL, la UVM es la institución con el mayor número de programas de excelencia a nivel nacional. Ofrece formación a nivel bachillerato, licenciatura, técnico superior universitario, maestría y postgrados, en disciplinas tales como medicina y ciencias de la salud, ingeniería, tecnologías de la información, derecho, arquitectura, negocios, gastronomía, diseño, educación y hospitalidad. Para más información visite: uvm.mx